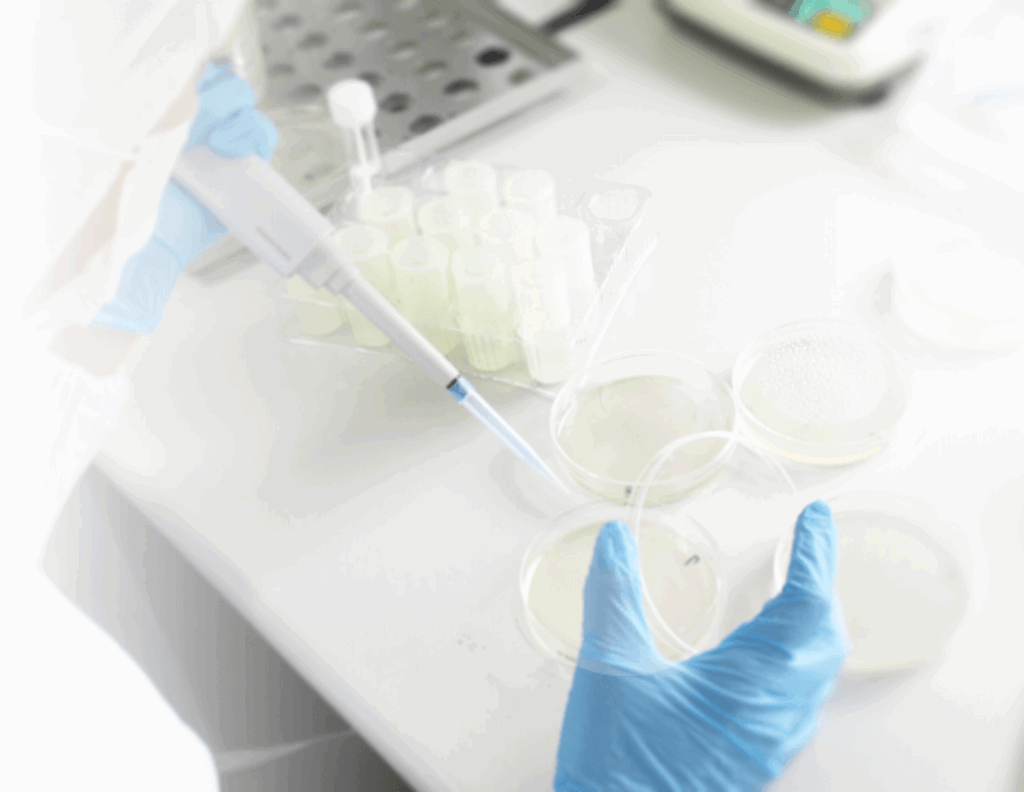

FOOD SERVICE & CATERING
給食・調理
約半世紀の実績と信頼
村上給食は、関西地域において約半世紀にわたってお弁当の配達サービスを提供してきた給食専門会社です。長年培ってきた経験と実績を基盤に、安全・安心なお弁当づくりを第一に掲げ、多くのお客様にご信頼いただいております。

一貫した品質管理体制
食材の選定からお客様のお手元へお届けするまで、仕入・製造・配送の全工程において一貫した安全管理体制を構築しています。社内には専門部署として製造部、物流部、購買部を設置し、さらに品質保証室が各部門の品質管理を統括することで、徹底した安全性の確保を実現しています。
HACCP準拠の製造管理
当社のお弁当製造は、国際的な食品安全管理システムであるHACCP(Hazard Analysis and Critical Control Points)に準拠しています。食品の原料受け入れから製造・出荷までの全工程において、危害の発生を防止するための重要ポイントを継続的に監視・記録する衛生管理手法を導入し、各工程を一般管理項目と重要管理項目に分類してリスク管理を徹底しています。また、厳格な出荷判定を実施し、全ての基準をクリアしたお弁当のみを出荷しております。
徹底した衛生管理システム
菌検査の実施
製造されたお弁当については、自社検査に加え外部検査機関による菌検査を定期的に実施し、二重のチェック体制により安全性を確保しています。
衛生講習会の開催
従業員全員を対象とした定期的な衛生講習会を実施しています。基本的な衛生管理から季節ごとの食中毒予防対策、アレルゲン管理、過去の食中毒事故事例の分析まで、幅広い内容で講習を行い、全従業員が共通の衛生知識を持てるよう努めています。
QC会議による継続的改善
各部署から選出されたメンバーによる品質管理会議を毎週開催し、社内全体の品質と衛生について継続的な話し合いを行っています。この会議を通じて、リスクマネジメントの強化と品質向上に向けた取り組みを推進しています。
栄養士による献立設計
お弁当の献立作成は、社内の管理栄養士が担当しています。お客様の健康に配慮した栄養バランスを重視し、肉・魚・野菜をバランス良く組み合わせた献立を提案しています。苦手な食材も美味しくお召し上がりいただけるよう、調理法や味付けに工夫を凝らし、日替わりメニューを通じて多様な栄養素を効率的に摂取していただけるよう配慮しています。
伝統と革新の調和
安全性を最優先としながら、調理の基本技術を大切に継承し、同時に時代のニーズに応じた新しい発想も積極的に取り入れています。この姿勢により、毎日お召し上がりいただいても飽きることのない、バラエティ豊かなお弁当づくりを実現しています。
職場と味のコミュニケーター
村上給食は、単なる食事の提供にとどまらず、「職場と味のコミュニケーター」として、お客様の職場環境をより豊かにすることを目指しています。美味しいお弁当を通じて、働く皆様の日々に彩りを添え、時代の変化に対応した新しい「食」のスタイルを提案し続けてまいります。
関西地域の多くの企業や施設で愛され続けている村上給食のお弁当を、ぜひ一度お試しください。
CONTACT
お問い合わせ
食欲研究所
TEL:06-6746-1050
